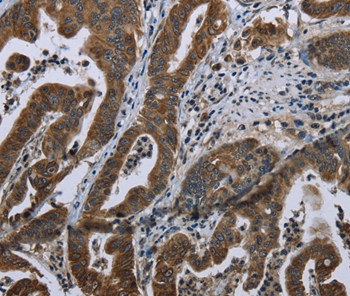

BRINP1 / DBC1 Antibody
LS-C812939
ApplicationsWestern Blot, ELISA
Product group Antibodies
TargetBRINP1
Overview
- SupplierLifeSpan BioSciences
- Product NameBRINP1 / DBC1 Antibody
- Delivery Days Customer14
- Application Supplier NoteApplications should be user optimized.
- ApplicationsWestern Blot, ELISA
- Applications SupplierELISA (1:10000 - 1:20000), WB (1:500 - 1:2000) Applications should be user optimized.
- CertificationResearch Use Only
- ClonalityMonoclonal
- ConjugateUnconjugated
- Estimated Purity...
- Gene ID1620
- Target nameBRINP1
- Target descriptionBMP/retinoic acid inducible neural specific 1
- Target synonymsbA574M5.1 (deleted in bladder cancer chromosome region candidate 1 (IB3089A)); BMP/retinoic acid-inducible neural-specific protein 1; bone morphogenetic protein/retinoic acid inducible neural-specific 1; bone morphogenic protein/retinoic acid inducible neural-specific 1; DBC1; DBCCR1; deleted in bladder cancer 1; deleted in bladder cancer chromosome region candidate 1; deleted in bladder cancer protein 1; FAM5A
- HostMouse
- IsotypeIgG1
- Storage Instruction-20°C
- UNSPSC12352203